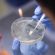

Covid, 122 nuovi casi
e altri quattro ricoveri nelle Marche

I nuovi casi sono 122, con quattro ricoveri in più e un decesso. E’ quanto emerge dal bollettino Covid del servizio Sanità della Regione. Nelle ultime 24 ore sono stati testati 3516 tamponi: 2153 nel percorso nuove diagnosi e 1363 nel percorso guariti. L’incidenza dei positivi è dunque al 5,7% (ieri era al 7,8%), mentre è leggermente in crescita il tasso di contagi ogni 100mila abitanti, arrivato a 44 contro 43 di ieri. La provincia con più contagi è Pesaro-Urbino (52), seguono: Ancona (26), Macerata (11), Ascoli (9), Fermo (9) e 15 da fuori regione. I sintomatici in tutta la regione sono 23. Sul fronte ospedaliero si registra un ricovero in più in terapia intensiva e tre in più nei reparti non intensivi. Ad oggi quindi i pazienti Covid nelle Marche sono 65: 18 in intensiva, 15 in semi-intensiva e 32 nei reparti non intensivi. A questi si aggiungono 5 persone nei pronto soccorso, di cui una a Macerata. Infine, è stata comunicata la morte di un 85enne di Serra de Conti, ricoverato a Fermo con patologie pregresse. Dopo il focolaio di contagio scoppiato nei giorni scorsi, sale a 5 il numero dei decessi tra gli anziani ospiti della casa di riposo di Rosora, tutti vaccinati e in attesa della terza dose. L’ultima anziana è deceduta ieri all’ospedale di Jesi, ‘Carlo Urbani’, dove era stata ricoverata in urgenza.
Torna alla home page